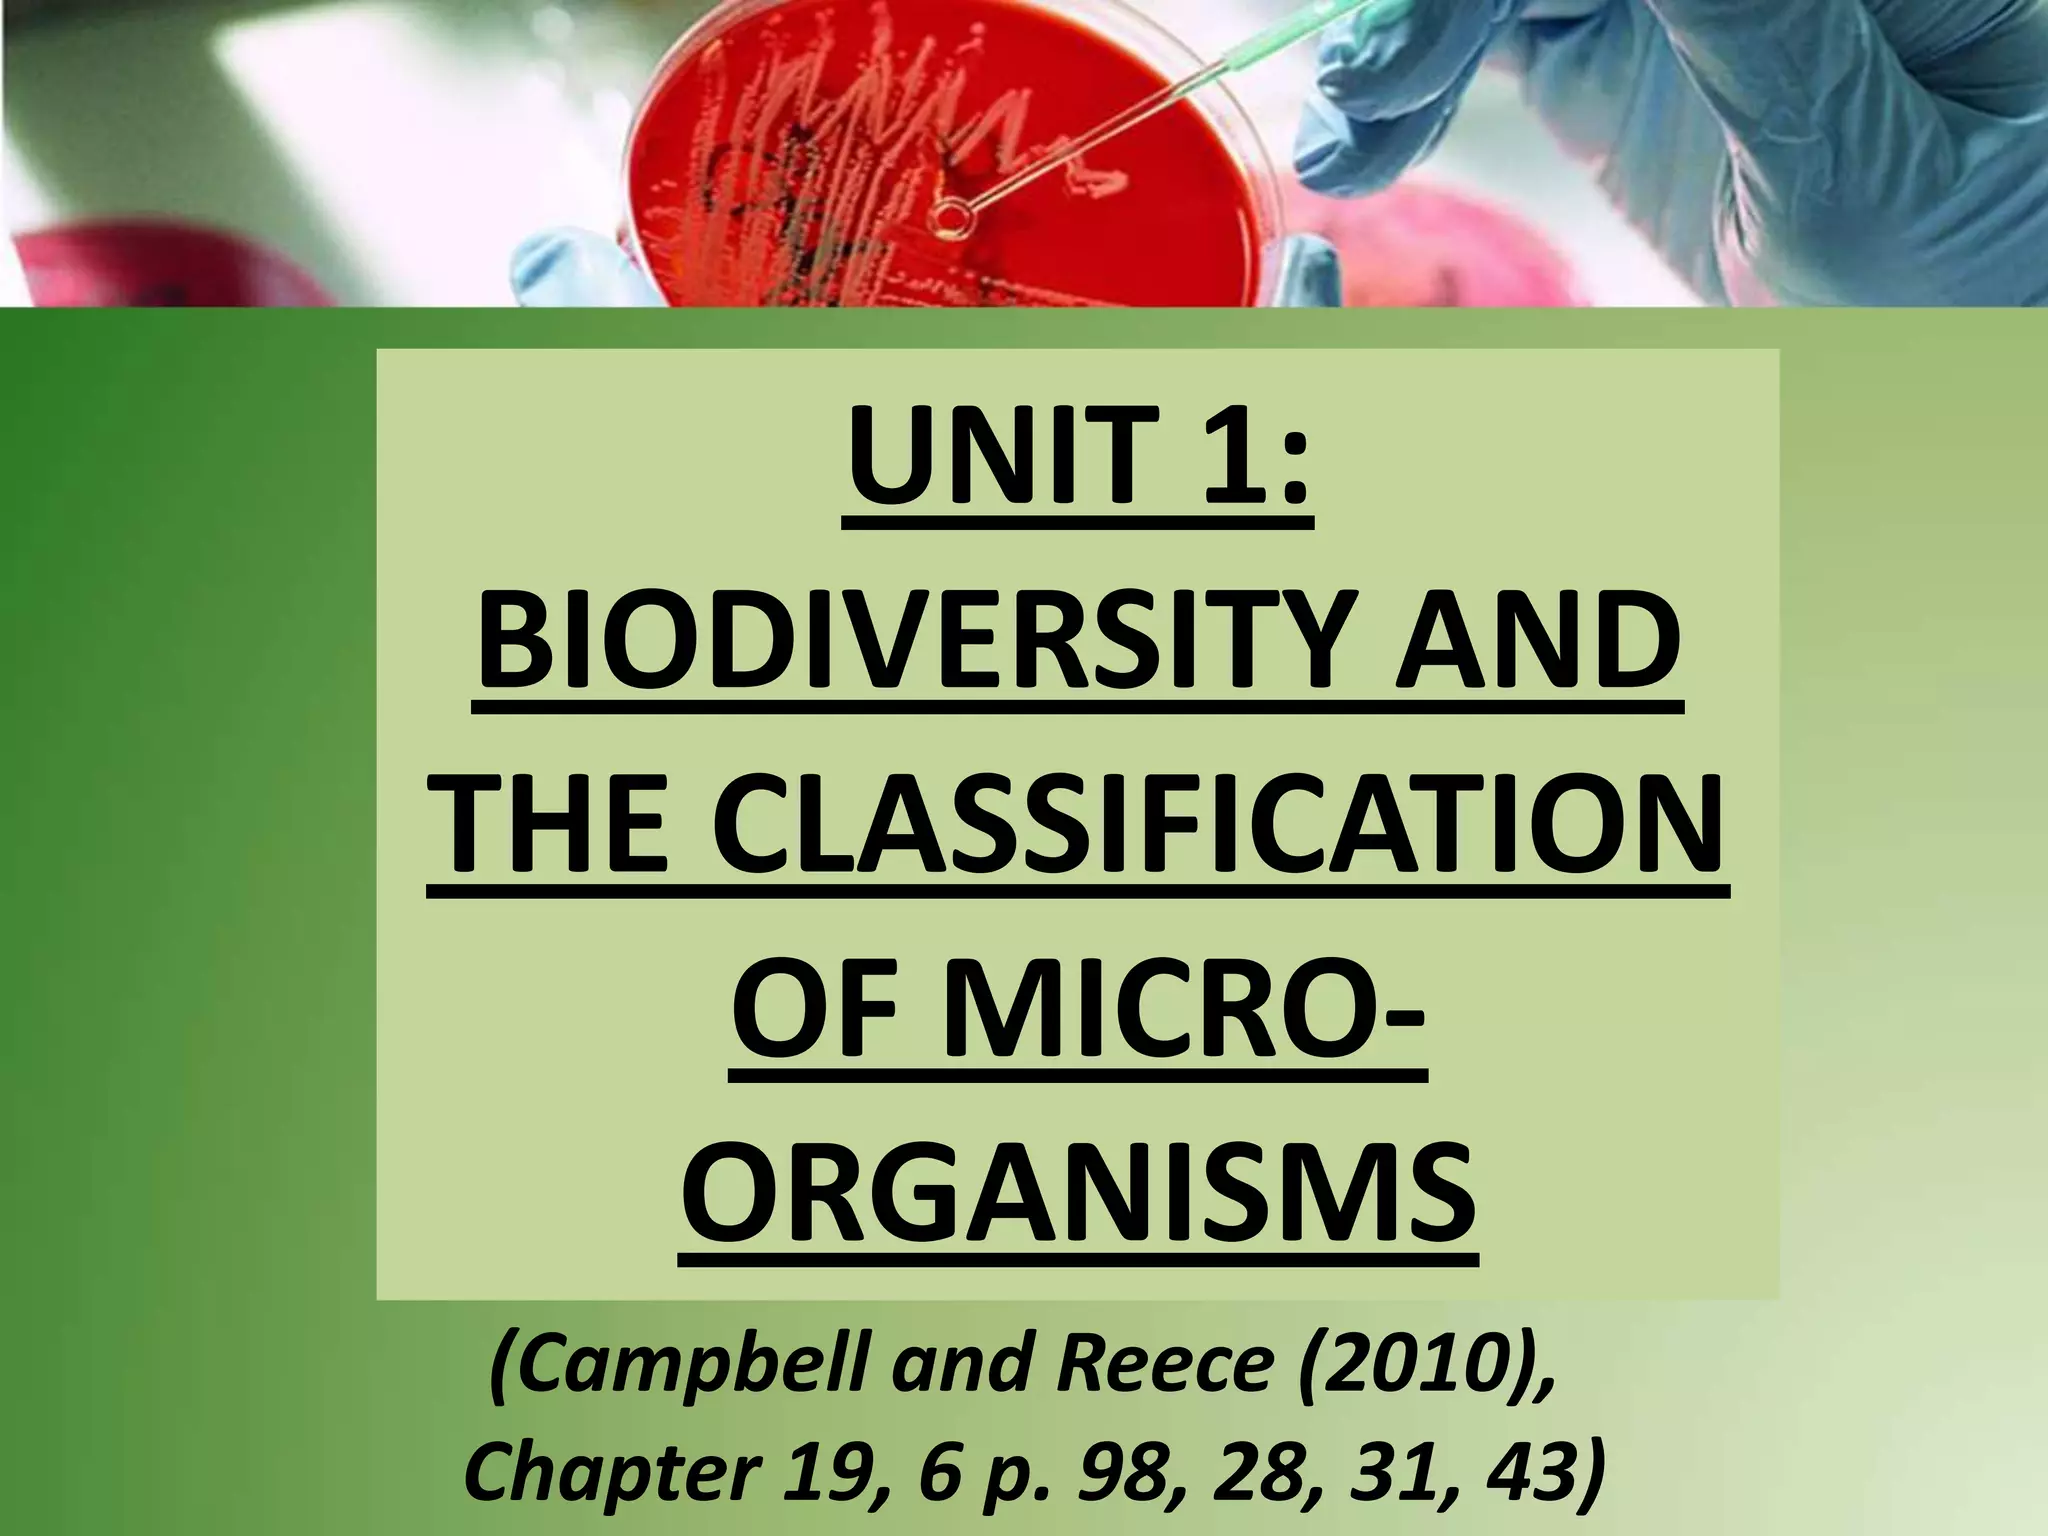
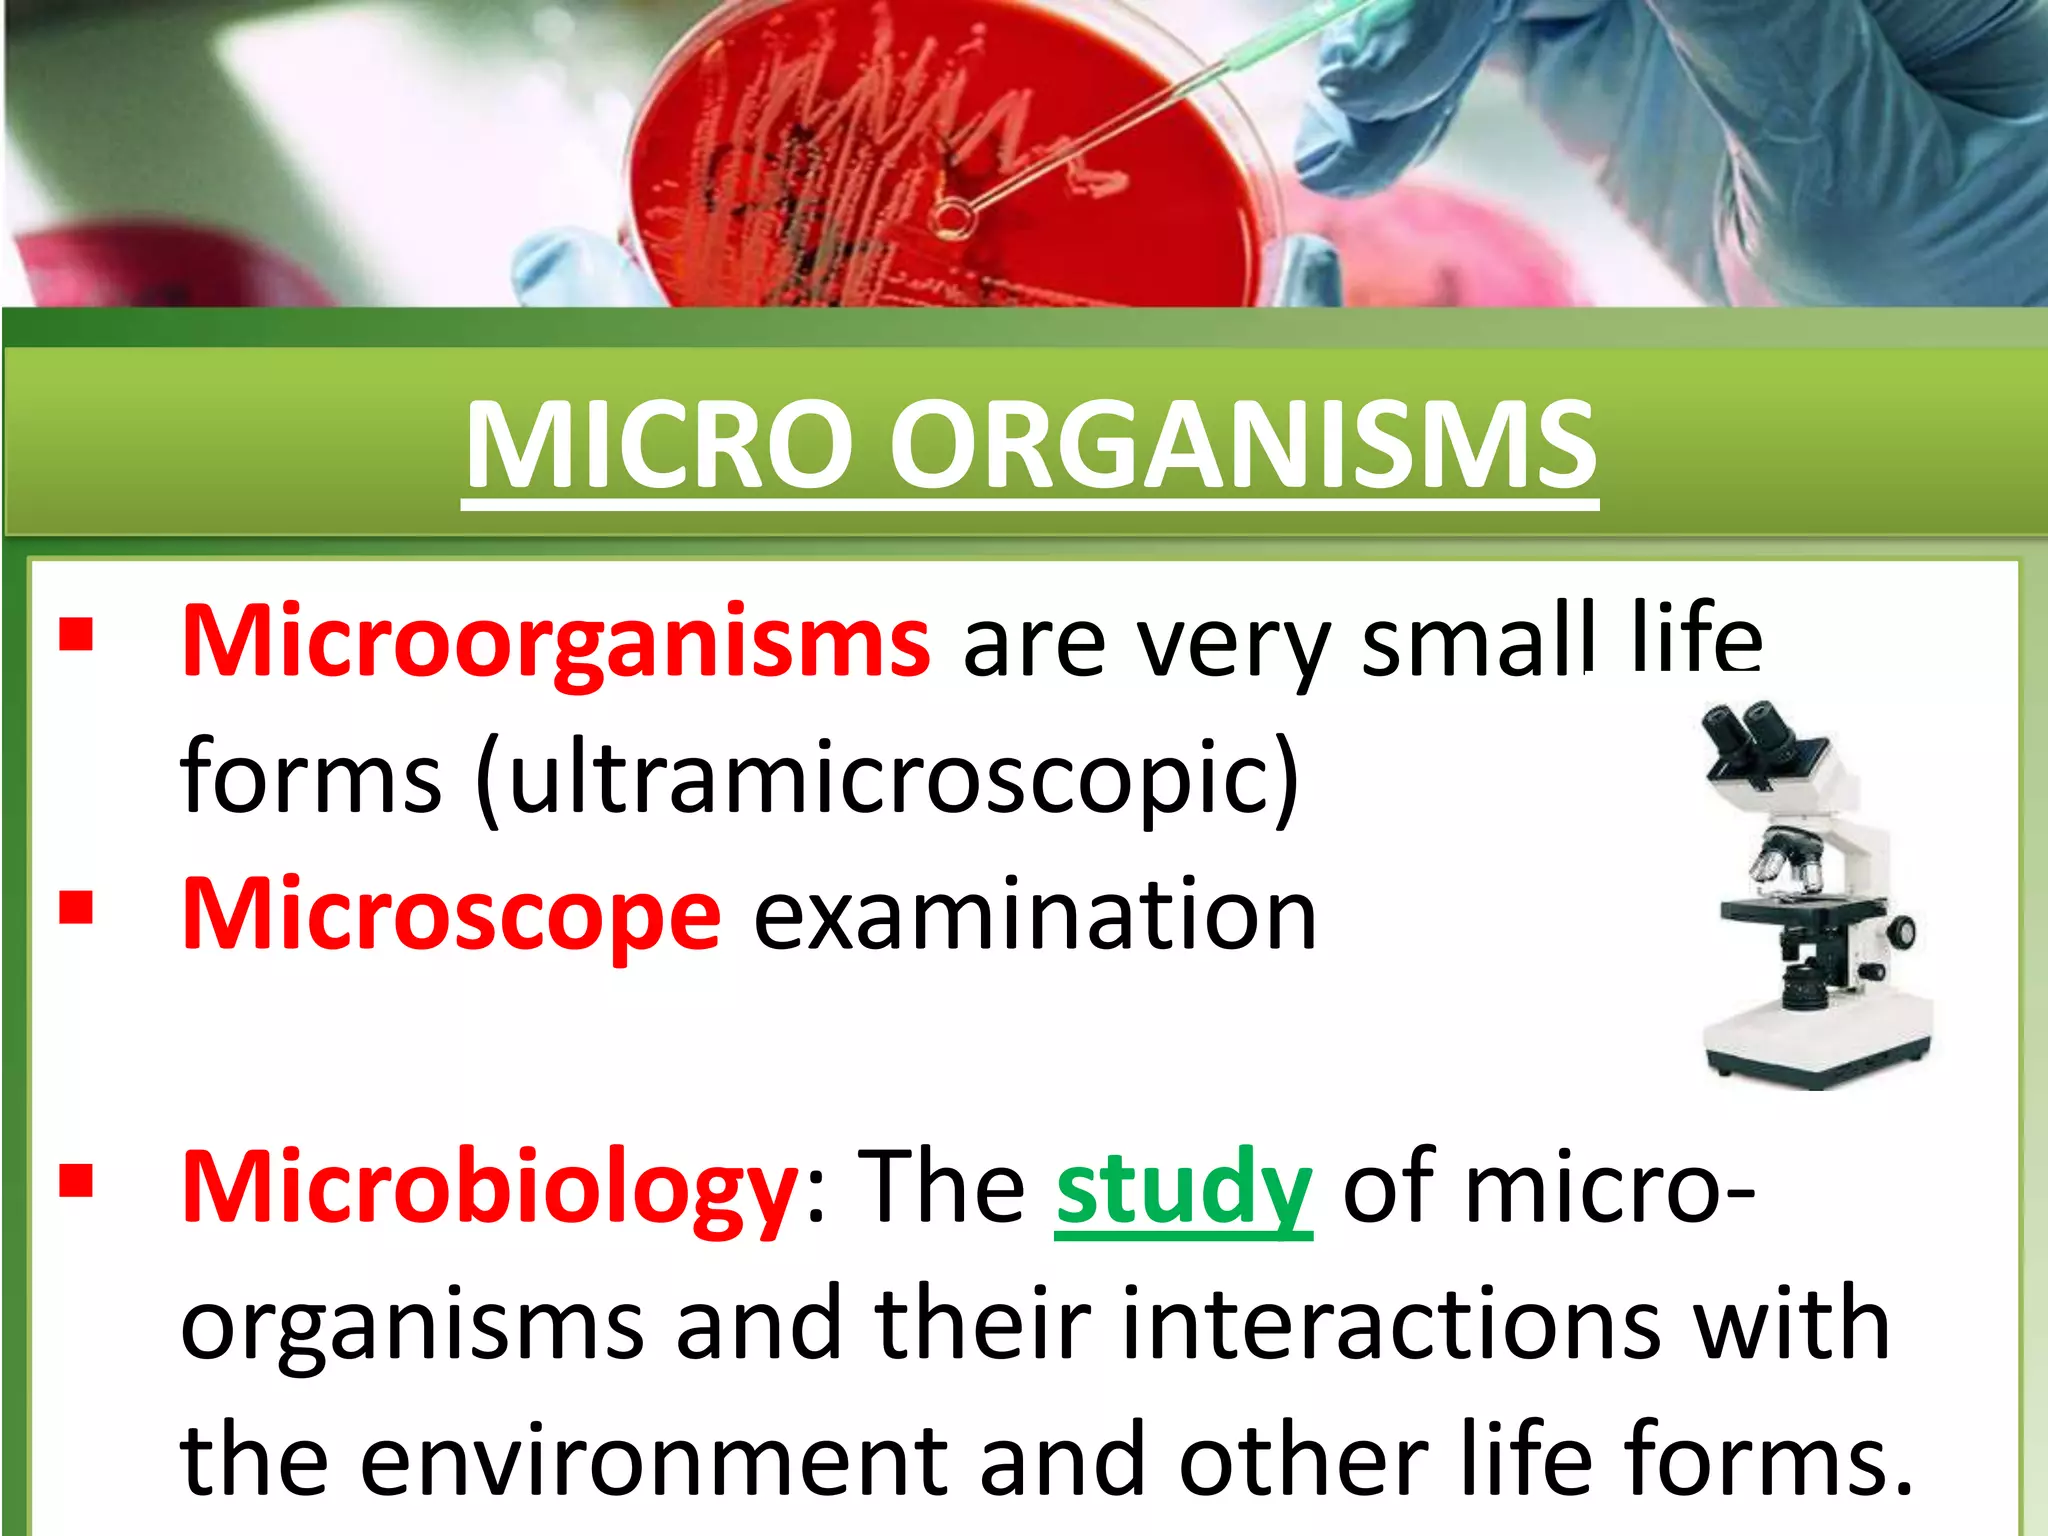

This document provides information on the classification and characteristics of microorganisms. It discusses the four main groups of microorganisms - viruses, bacteria, fungi, and protists. For each group, it describes their structure, reproduction methods, examples of important diseases or species, and how they are classified. The document also covers symbiotic relationships between microorganisms and plants.